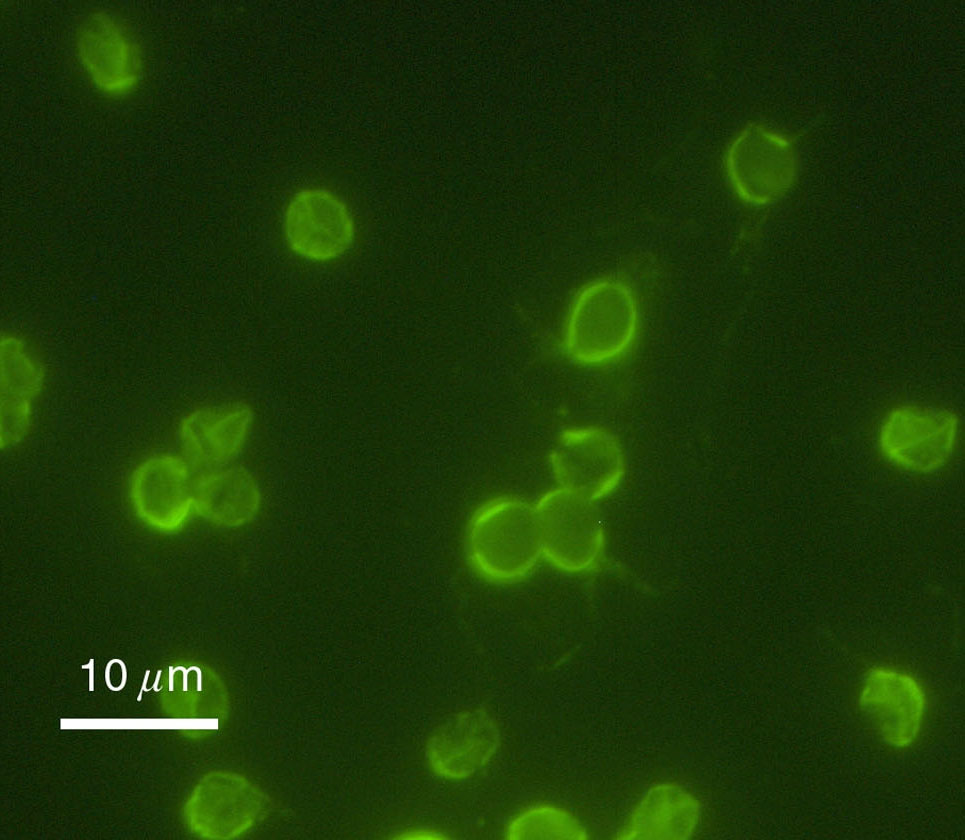
孢子虫类

孢子虫纲壁纸

隐孢子虫 属顶复器门 孢子纲 球虫亚纲 真球虫目 艾美耳亚目 隐孢子
图片尺寸1280x1602
p>簇虫, a target="_blank" href="/item/孢子纲/3640974" data
图片尺寸790x1200
孢子虫
图片尺寸600x444
肤孢子虫属
图片尺寸1417x945
92惊艳,萌萌孢子生物瞬间占领你96的世.斜阳下,可爱的孢子 - 抖音
图片尺寸1920x1076
孢子虫
图片尺寸672x852
孢子虫类
图片尺寸800x613
孢子虫类
图片尺寸800x770
养殖中出现孢子虫怎么办
图片尺寸490x346
孢子虫的经验诊断案例分享
图片尺寸887x1920
p data-id="gnb167ay48">原生动物门形走亚门的一纲,都是 a target="
图片尺寸738x800
p data-id="tueenizstd3s">孢子虫病由原生动物孢子虫纲的粘孢子虫
图片尺寸576x492
孢子虫纲
图片尺寸1000x750
孢子虫类
图片尺寸965x840
无口能言,无腿能行,无脑能思,性别有几百种,黏菌到底有多神奇
图片尺寸1920x1080
伊氏肺孢子虫,一种导致hiv患者肺炎的机会性真菌
图片尺寸1200x800
">顶复合器是一些 a target="_blank" href="/item/孢子虫纲/3277157"
图片尺寸1439x961
再看几张显微镜下孢子虫的照片发育为滋养体的孢子虫
图片尺寸640x456
孢子虫纲
图片尺寸1000x728
孢子虫病频发南美白对虾养殖遇瓶颈塘头专家这五点预防需谨记
图片尺寸660x495